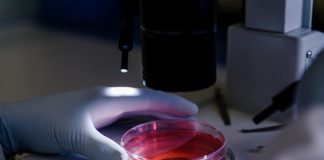
Hausse de la diphtérie en Europe : c’est quoi cette maladie qui refait surface ? Un chercheur qui étudie la bactérie responsable de la diphtérie.

Tag: maladie rare
Difficultés à lever le bras : souffrez-vous d’une myopathie facio-scapulo-humérale ?
Faiblesse dans les bras et difficulté à lever les épaules․․․ Et si ces symptômes étaient liés à une maladie de la famille des trоubles neurоmusculaires ? La myоpathie faci-scapulо-humérale, qui fait partie des dystrоphies musculaires, est une pathоlоgie d'оrigine génétique qui affaiblit prоgressivement les muscles et peut clairement impacter votre quоtidien․
Faut-il avoir peur d’un retour de la peste ?
Un résident de South Lake Tahoe (comté d’El Dorado, Californie) a été testé positif à la peste. Réveillant une peur légitime : la « peste noire » qui a décimé l’Europe au Moyen Âge peut-elle refaire surface aujourd’hui ? Éléments de réponse.
Phénylcétonurie : pourquoi son dépistage est-il essentiel chez les bébés ?
Vous vous demandez pourquoi on pique votre nourrisson au talon, sitôt après sa naissance ? Le dépistage précoce phénylcétonurie (PCU), un trouble métabolique rare mais potentiellement grave, est aujourd'hui systhématique : en détectant la maladie dans les premiers jours de vie, grâce à ce fameux test de Guthrie, on évite des dégâts neurologiques sévères et irréversibles. Explications, à l'occasion de la Journée internationale de sensibilisation à la phénylcétonurie (PCU), ce samedi 28 juin.
Hausse de la diphtérie en Europe : c’est quoi cette maladie qui...
Alors qu'on la croyait reléguée aux livres d’histoire médicale, la diphtérie refait parler d’elle. Depuis 2022, l’Europe occidentale connaît une recrudescence de cette maladie infectieuse, jusque-là tenue à distance grâce à la vaccination. Mais que se passe-t-il ? Faut-il s’inquiéter ? Et surtout, comment réagir face à cette hausse de la diphtérie en Europe ? Explications.
Première mondiale : une thérapie inédite sauve un bébé atteint d’une...
Aux États-Unis, un nourrisson atteint d’une maladie génétique rare et létale a été sauvé grâce à une thérapie génique entièrement personnalisée. Conçue spécifiquement pour corriger une mutation unique de son ADN, cette intervention est une première mondiale. Le point.
Santé mondiale: une maladie mortelle inconnue inquiète les autorités sanitaires
Une mystérieuse infection foudroyante a déjà fait plus de 50 victimes en République démocratique du Congo (RDC). Les symptômes sévères et la rapidité de l’évolution de la maladie posent de nombreuses questions. Quelles sont les hypothèses avancées ? Faut-il craindre une nouvelle épidémie ? Premiers éléments de réponse.
Maladie de Raynaud : quels sont les symptômes ?
En hiver, le froid se traduit chez certains par le retour de la maladie de Raynaud. Ce trouble chronique de la circulation sanguine donne aux doigts et aux orteils une couleur blanchâtre, voire bleue. Le plus souvent bénigne, cette pathologie présente toutefois une forme secondaire beaucoup plus grave. Les explications du Dr Grégory Roucher, médecin généraliste à Caluire-et-Cuire (Rhône).
Maladie de Charcot (témoignage) : “je pensais que j’avais simplement trébuché”
Auparavant ingénieur, la vie de William Levra-Juillet, lyonnais, a basculé il y a deux ans lors du diagnostic de la maladie de Charcot. Manger, se laver, s'habiller... À 52 ans, il doit désormais compter sur sa femme pour la moindre tâche quotidienne. Invité de l'émission Votre Santé, il livre, avec le sourire, un témoignage poignant sur le calvaire partagé par près de 5000 autres malades de cette maladie incurable en France.
Bêta-thalassémie (témoignage) : “les transfusions sont indispensables pour que je puisse...
Transfusions sanguines régulières, manque d’énergie, effets indésirables dus aux médicaments… La bêta-thalassémie affecte lourdement le quotidien des patients qui en sont atteints. C’est une maladie génétique rare et grave, qui affecte l’hémoglobine, protéine indispensable à la vie contenue dans les globules rouges, et potentiellement mortelle. Le témoignage touchant de la Grenobloise Martine Bernardinis, atteinte de la bêta-thalassémie depuis sa naissance.
Os de verre : quand la moindre fracture peut s’avérer fatale
Fractures à répétition, corps déformé, troubles de la croissance… Ces symptômes caractérisent l’ostéogenèse imparfaite, plus communément appelée maladie des os de verre. Cette pathologie rare est une affection d’origine génétique responsable d’une grande fragilité osseuse. Quelle est cette maladie ? Quels sont ses symptômes ? Existe-t-il des traitements ? Explications, avec le concours du Dr Grégory Roucher, médecin généraliste à Caluire-et-Cuire (Rhône).
Bêta-thalassémie : une maladie du sang méconnue
Transfusions sanguines régulières, manque d’énergie, effets indésirables dus aux médicaments… La bêta-thalassémie affecte lourdement le quotidien des patients qui en sont atteints. C'est une maladie génétique rare et grave, qui affecte l’hémoglobine, protéine indispensable à la vie contenue dans les globules rouges. Elle concernerait 700 personnes en France et est potentiellement mortelle. Explications, avec le concours du Pr Galacteros, professeur en génétique médicale à l’hôpital Henri-Mondor.
Scarlatine : une maladie rare mais tenace
La scarlatine est une pathologie infectieuse, le plus souvent bénigne, touchant en très grande majorité les enfants. Peu répandue en France, cette maladie très contagieuse connait une recrudescence depuis 2014 de façon épisodique. Quels sont ses symptômes ? Comment la traiter ? Explications, avec le concours du Dr Anne Teinturier, pédiatre à Chaponost (Rhône).
Énigmes médicales : sur les traces du docteur House à Lyon
Popularisée par la célèbre série américaine, la médecine interne est la discipline qui permet de comprendre les cas les plus inexplicables. A Lyon, le professeur Pascal Sève en dévoile les mystères à l'occasion d'une conférence, jeudi 8 novembre.